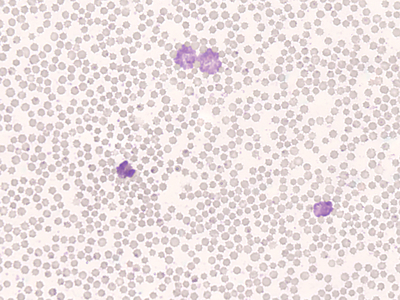

Cow Blood Smear ,Each
$ 5.41
|
|
Details:
COW BLOOD SMEAR
Additional Information
| SKU | 23377641 |
|---|---|
| UOM | EACH |
| UNSPSC | 41123202 |
| Manufacturer Part Number | WARD470177-124 |
| Product Dimensions | 3X0.05X1 Inches |
| Product Weight | 0.05 |
